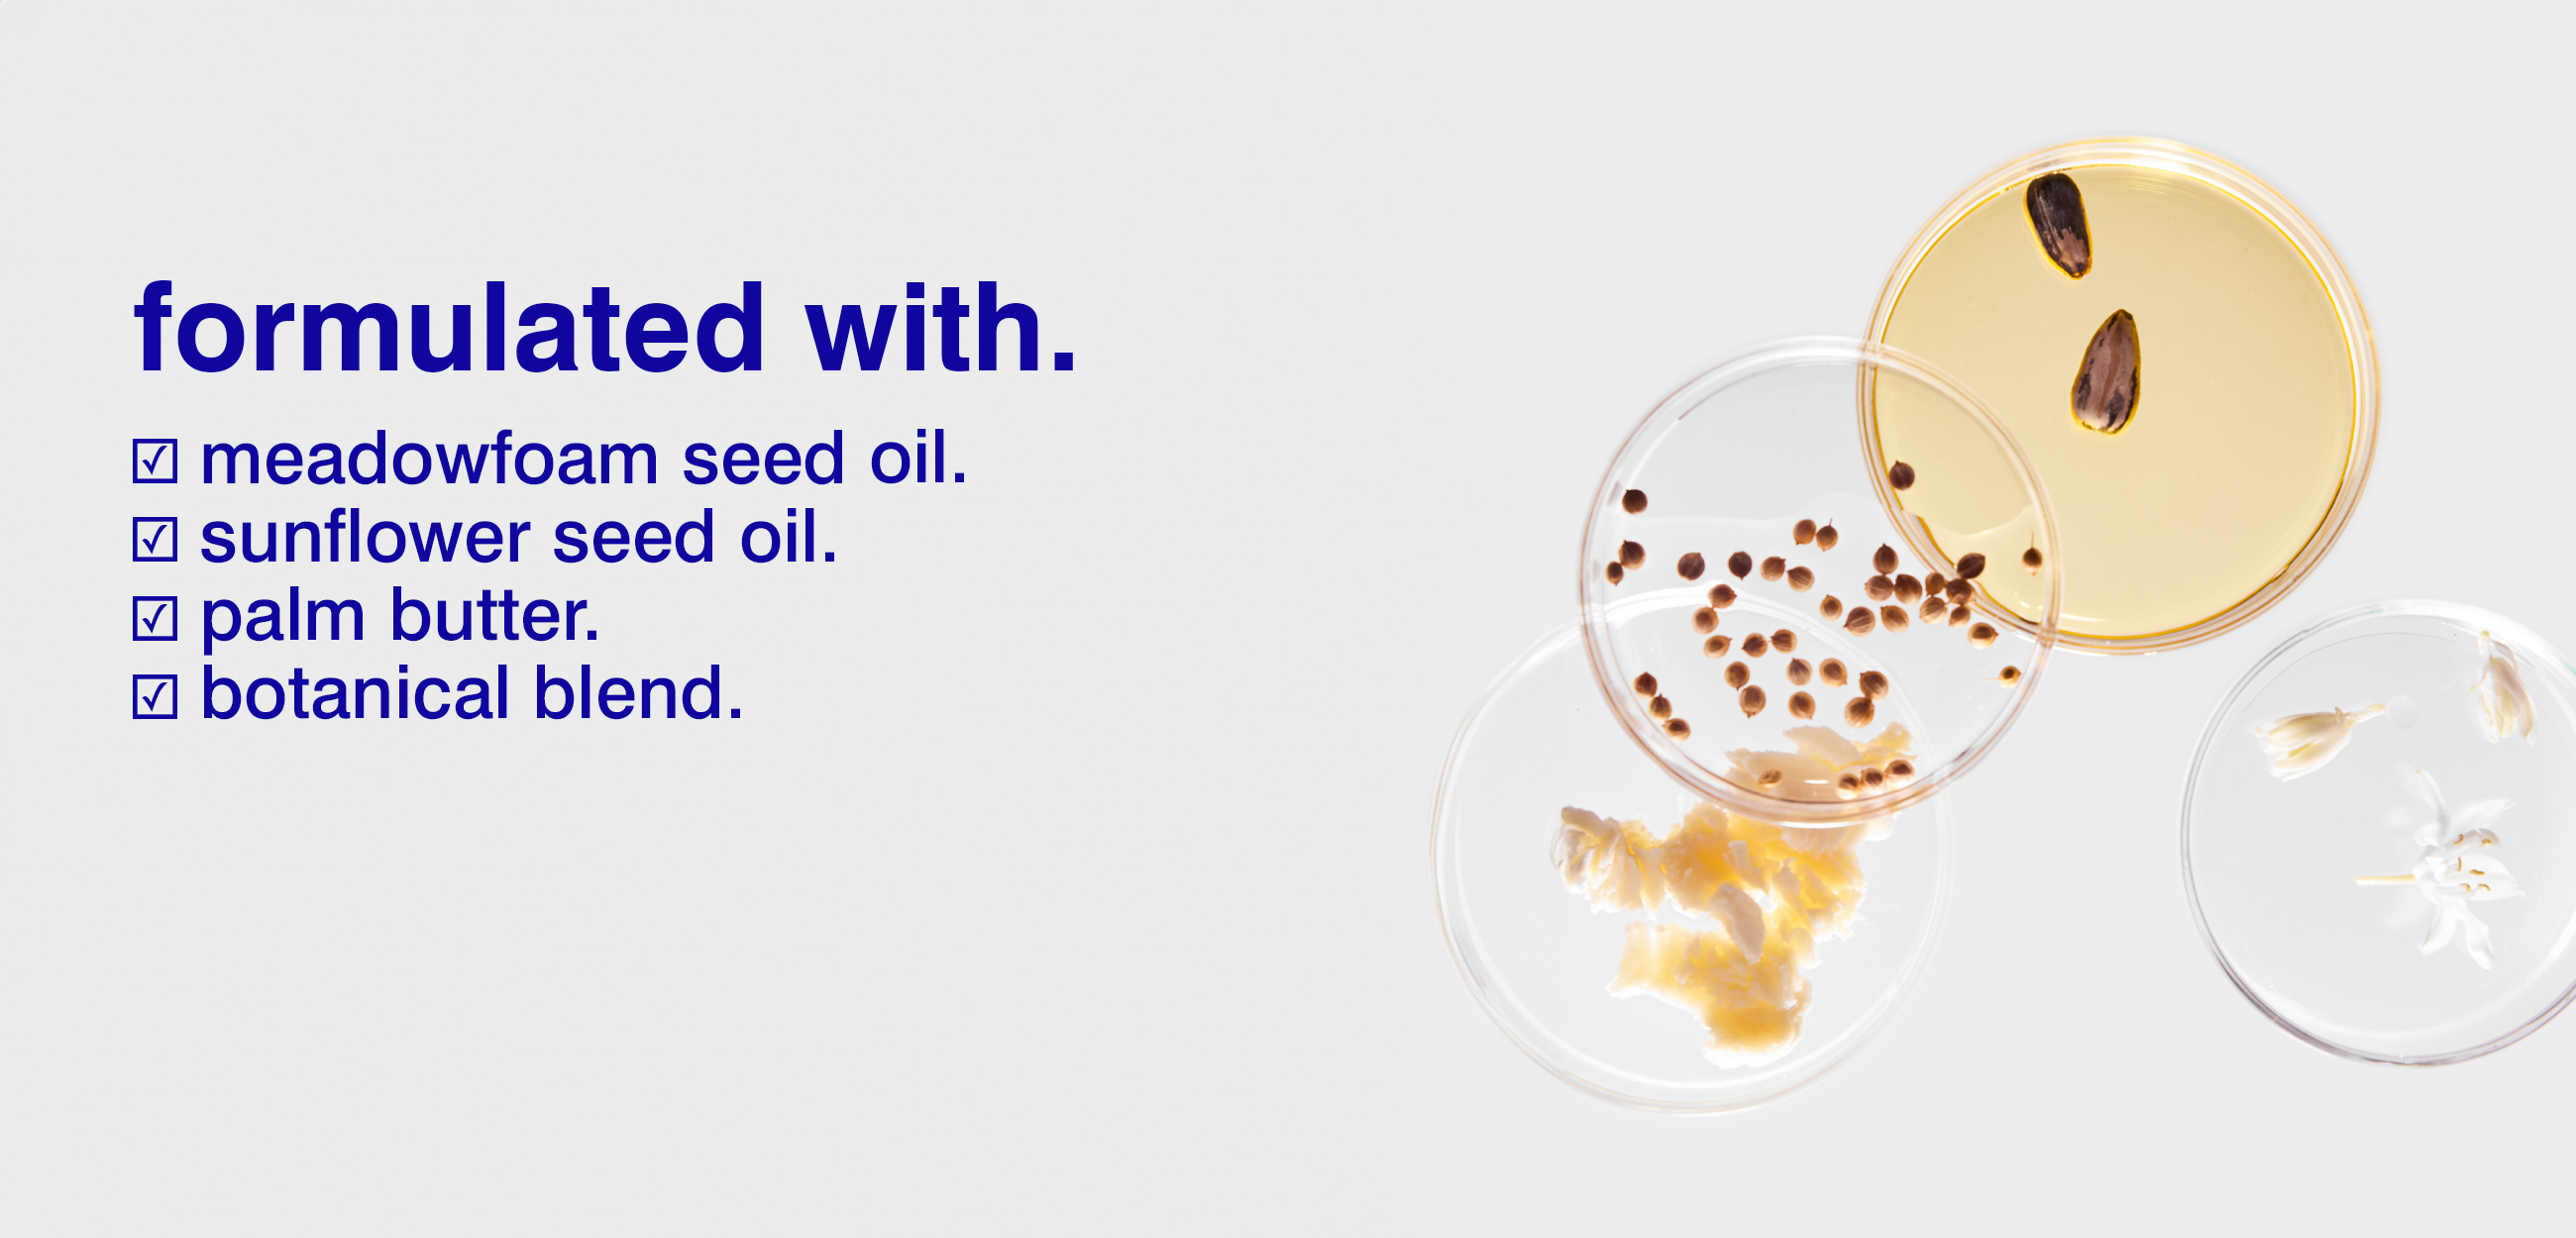
all-purpose moisture formulated without

all-purpose moisture balm.
a deeply nourishing, multi-purpose balm formulated to support skin by providing rich moisture and comfort to soothe dry, dehydrated skin for all over the body. proven to support the skin barrier and moisturization for 12 hours*.
£18
BENEFITS.
what it is.
our deeply nourishing, multi-purpose moisture balm is formulated with 17 botanicals + butters delivering targeted relief to dry, dehydrated skin. this ultra-rich formula starts as a lush balm that melts into a lightweight, dry-touch oil to provide comforting hydration without heaviness or residue. safe + effective to use from head to toe, it’s a skin-first essential that soothes, softens + seals in moisture wherever you need it most.
why you need it.
more than just hydration, this multi-tasking balm adapts to your skin’s needs. rich yet breathable, it targets dry patches, chapped lips, rough cuticles, and more anywhere, anytime. packaged in a mess-free aluminum tube, it’s flexible, layers easily, and works seamlessly with your routine.
clinical results*
+ proven to improve the skin barrier + moisturization after one use
+ 94% improvement in skin smoothness after one use
+ 100% agreed skin looks healthy
+ 100% agreed product left skin feeling soft + smooth
+ 100% agreed product doesn’t feel sticky/ greasy
+ 100% agreed product absorbed quickly into skin
*based on a clinical study conducted on 34 subjects with various skin types over a 12-hour period.
key ingredients.
+ meadowfoam seed oil prevents moisture loss while leaving a soft, non-greasy finish.
+ sunflower seed oil helps support the skin’s natural barrier, locking in moisture.
+ plum seed oil butter hydrates, protects, and restores the skin.
+ botanical blend nourishes skin and provides a soothing aromatic experience.
INGREDIENTS.
helianthus annuus (sunflower) seed oil, simmondsia chinensis (jojoba) oil, hydrogenated vegetable oil, butyrospermum parkii (shea) butter, beeswax/cera alba/cire d'abeille,persea gratissima (avocado) oil, limnanthes alba (meadowfoam) seed oil, oryza sativa (rice) bran extract,prunus domestica seed oil, caprylyl glycol, 1,2-hexanediol, hydrogenated prunus domestica seed oil, linoleic acid, helianthus annuus (sunflower) seed wax, geranium maculatum oil, lavandula angustifolia (lavender) oil, carthamus tinctorius (safflower) seed oil, helianthus annuus (sunflower) extract, linolenic acid, citrus aurantium dulcis (orange) peel extract, glycine soja (soybean) oil, pelargonium graveolens extract, tocopherol, rosmarinus officinalis (rosemary) leaf extract, citrus aurantifolia (lime) peel extract, cymbopogon martini oil, geranium maculatum extract, lavandula angustifolia (lavender) flower/leaf/stem extract, mentha viridis (spearmint) extract, withania somnifera root extract, curcuma longa (turmeric) root extract, coriandrum sativum (coriander) extract, citrus grandis (grapefruit) fruit extract, rose extract.
DIRECTIONS.
warm the balm between fingers + apply anywhere skin needs extra care.
all-purpose uses.
+ face. dry lips, nose + ears, after-sun treatment, aftershave balm, beard conditioner, makeup primer or remover, overnight mask, brow groomer.
+ body. treat rough elbows, knees + feet, hand + cuticle treatment, tattoo conditioner, massage oil, add radiance anywhere skin catches the light like legs, shoulders, collarbone + bow of the lips.
+ hair. smooth ends, tame flyaways + add shine.

- cleanse without overdrying.
- modern + minimalist design.
- sophisticated scents to choose from: bergamot, rum, eucalyptus + cannabis.


